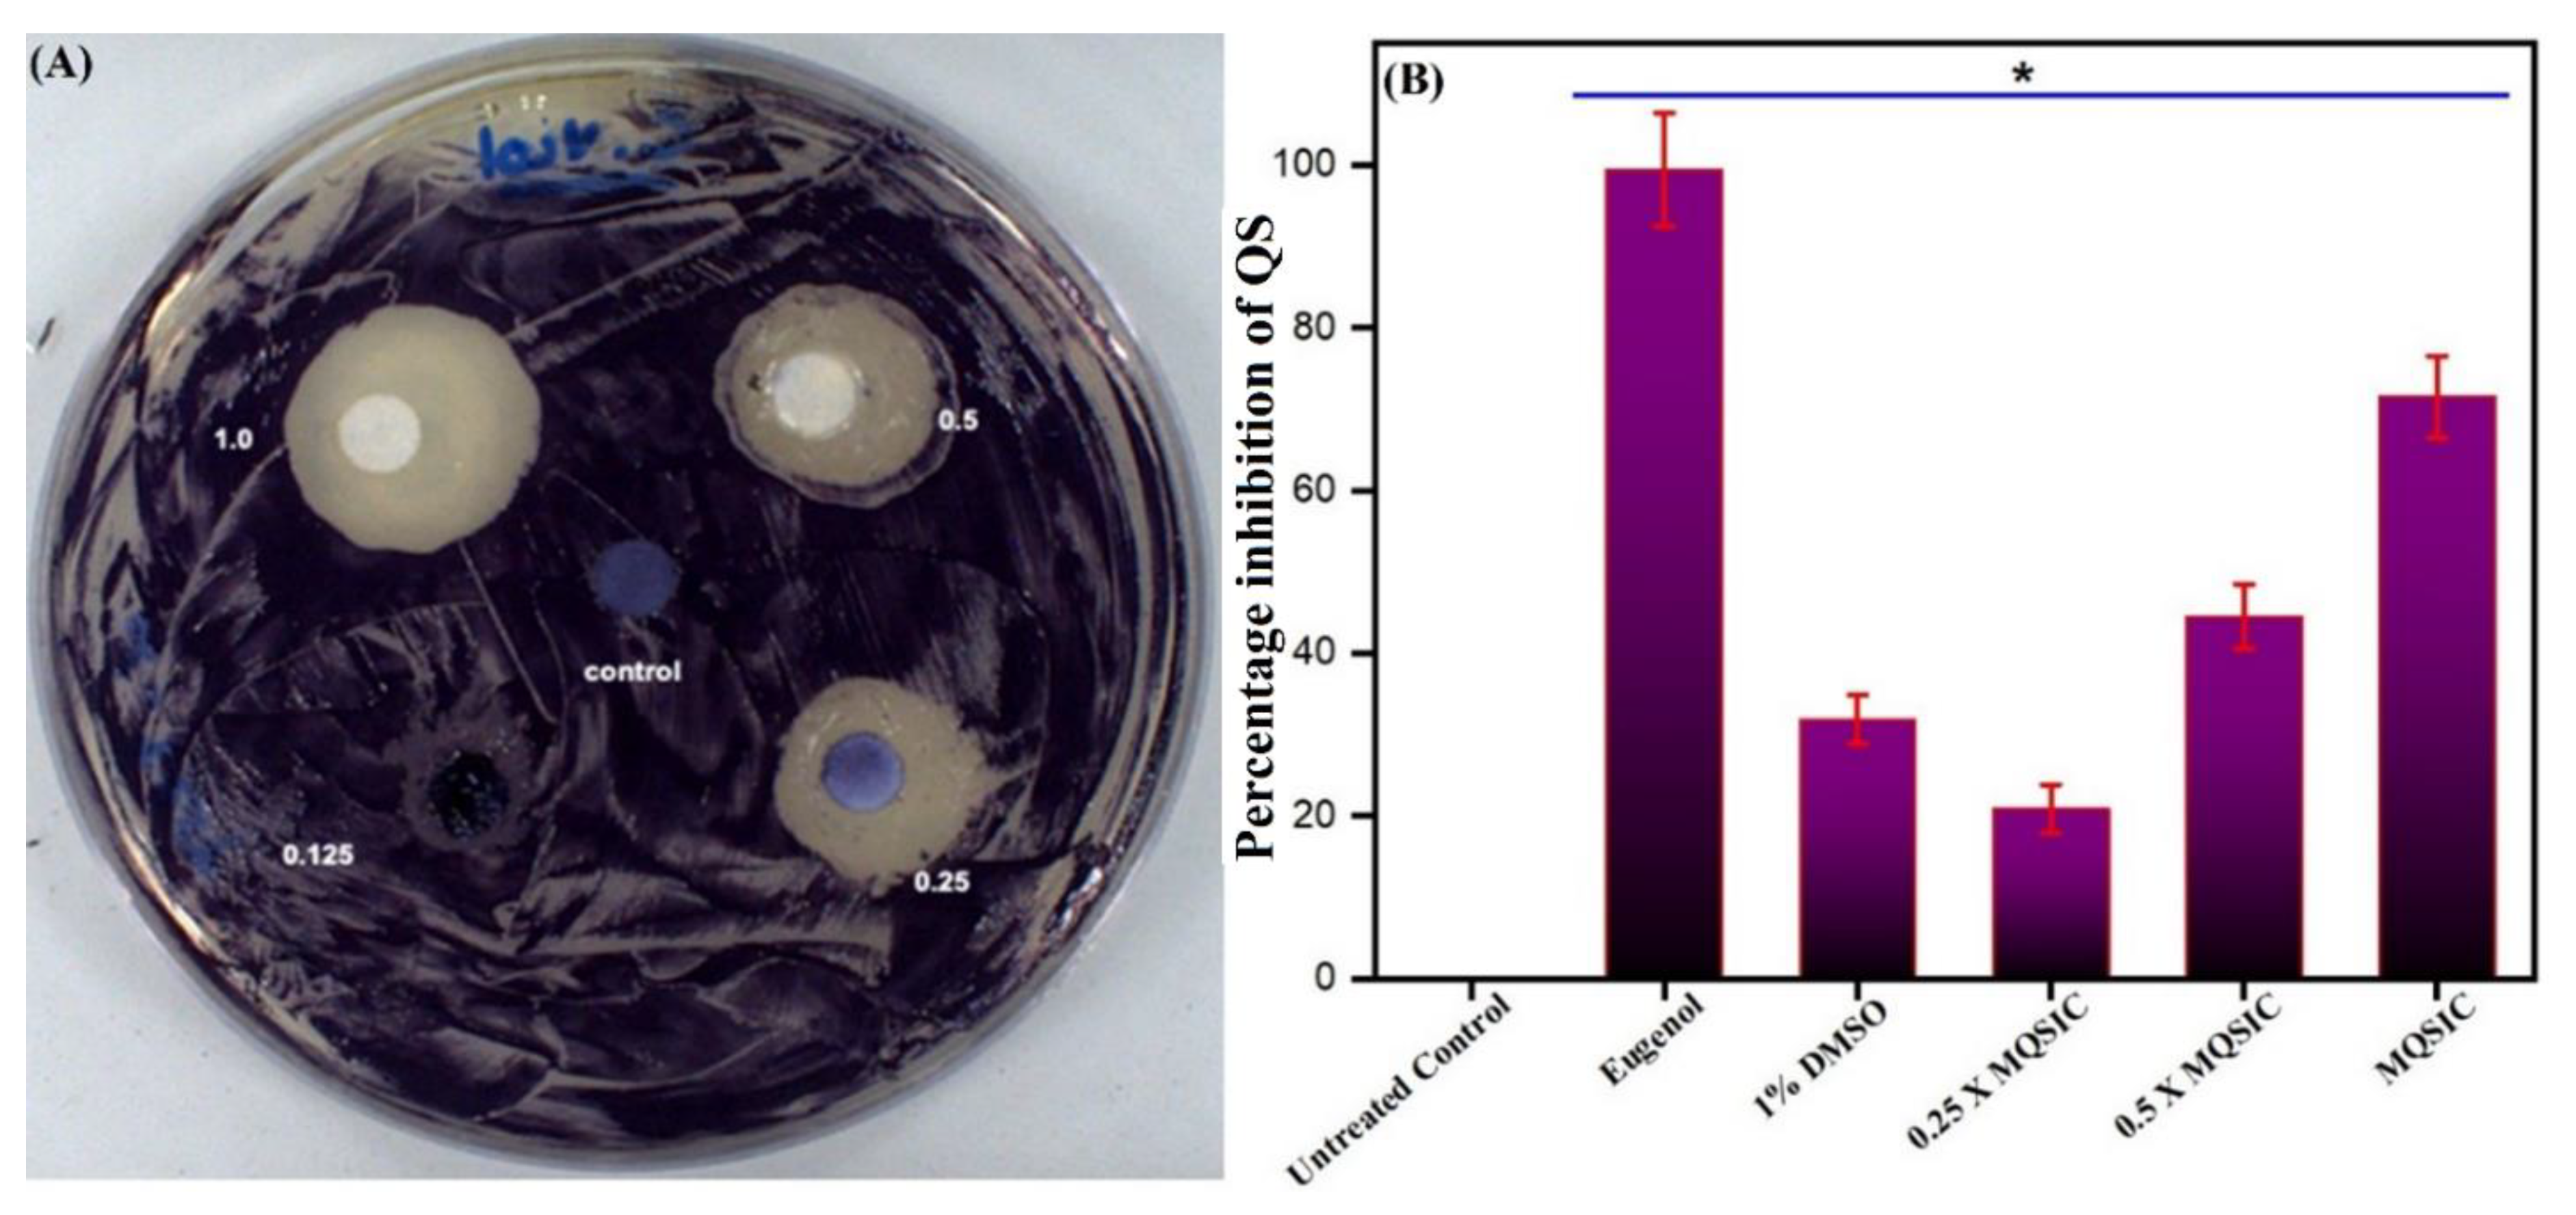

Biogenic ZnO Nanoparticles Synthesized from Origanum vulgare Abrogates Quorum Sensing and Biofilm Formation in Opportunistic Pathogen Chromobacterium violaceum
Abstract
:1. Introduction
2. Materials and Methods
2.1. Chemicals
2.2. Preparation of Aqueous Leaf Extract of Origanum vulgare
2.3. Synthesis of ZnO NPs Using Origanum vulgare Extract
2.4. Characterization of Biogenic ZnO NP
2.5. Bacterial Strain and Growth Conditions
2.6. Antimicrobial and Antiquorum-Sensing Testing
2.7. Antiquorum-Sensing Activity
2.8. Qualitative Antiquorum-Sensing Activity
2.9. Quantitative Antiquorum-Sensing Activity
2.10. Biofilm Inhibition Assay
2.11. Confocal Laser Scanning Microscopy (CLSM)
2.12. Gene Expression
2.13. Statistics
3. Results and Discussion
3.1. Structural Characterization
3.2. Morphology of ZnO NPs
3.3. UV-Vis Spectroscopy of ZnO-NPs
3.4. FTIR Analysis of Biogenic ZnO NPs
3.5. Probable Biosynthetic Mechanism of ZnO NPs upon Fabrication in Origanum vulgare Extract
3.6. TGA-DTG Analysis of Biogenic ZnO NPs
3.7. Antimicrobial Susceptibility Testing
3.8. Antiquorum-Sensing Property
3.9. Biofilm Inhibition Activity
3.10. Confocal Laser Scanning Microscopy (CLSM)
3.11. Effect on Quorum Sensing-Associated Marker Genes
4. Conclusions
Supplementary Materials
Author Contributions
Funding
Institutional Review Board Statement
Informed Consent Statement
Data Availability Statement
Acknowledgments
Conflicts of Interest
References
- Meruvu, S.; Hugendubler, L.; Mueller, E. Regulation of adipocyte differentiation by the zinc finger protein ZNF638. J. Biol. Chem. 2011, 286, 26516–26523. [Google Scholar] [CrossRef] [Green Version]
- Iravani, S.; Korbekandi, H.; Mirmohammadi, S.V.; Zolfaghari, B. Synthesis of silver nanoparticles: Chemical, physical and biological methods. Res. Pharm. Sci. 2014, 9, 385. [Google Scholar]
- Magdalane, C.M.; Kaviyarasu, K.; Vijaya, J.J.; Siddhardha, B.; Jeyaraj, B. Photocatalytic activity of binary metal oxide nanocomposites of CeO2/CdO nanospheres: Investigation of optical and antimicrobial activity. J. Photochem. Photobiol. B Biol. 2016, 163, 77–86. [Google Scholar] [CrossRef]
- Bhosale, T.; Shinde, H.; Gavade, N.; Babar, S.; Gawade, V.; Sabale, S.; Kamble, R.; Shirke, B.; Garadkar, K. Biosynthesis of SnO 2 nanoparticles by aqueous leaf extract of Calotropis gigantea for photocatalytic applications. J. Mater. Sci. Mater. Electron. 2018, 29, 6826–6834. [Google Scholar] [CrossRef]
- Kumar, M.; Dandapat, S.; Kumar, A.; Sinha, M. Determination of nutritive value and mineral elements of five-leaf chaste tree (Vitex negundo L.) and Malabar nut (Adhatoda vasica Nees). Acad. J. Plant Sci. 2013, 6, 103–108. [Google Scholar]
- Jayarambabu, N.; Rao, K.V.; Rajendar, V. Biogenic synthesis, characterization, acute oral toxicity studies of synthesized Ag and ZnO nanoparticles using aqueous extract of Lawsonia inermis. Mater. Lett. 2018, 211, 43–47. [Google Scholar] [CrossRef]
- Rudramurthy, G.R.; Swamy, M.K.; Sinniah, U.R.; Ghasemzadeh, A. Nanoparticles: Alternatives against drug-resistant pathogenic microbes. Molecules 2016, 21, 836. [Google Scholar] [CrossRef] [PubMed]
- Lucilha, A.C.; Silva, M.R.d.; Ando, R.A.; Dall’Antonia, L.H.; Takashima, K. ZNO and AG-ZNO crystals: Synthesis, characterization, and application in heterogeneous photocatalysis. Química Nova 2016, 39, 409–414. [Google Scholar] [CrossRef]
- Suo, B.; Li, H.; Wang, Y.; Li, Z.; Pan, Z.; Ai, Z. Effects of ZnO nanoparticle-coated packaging film on pork meat quality during cold storage. J. Sci. Food Agric. 2017, 97, 2023–2029. [Google Scholar] [CrossRef]
- Galstyan, V.; Bhandari, M.P.; Sberveglieri, V.; Sberveglieri, G.; Comini, E. Metal oxide nanostructures in food applications: Quality control and packaging. Chemosensors 2018, 6, 16. [Google Scholar] [CrossRef] [Green Version]
- Qi, K.; Cheng, B.; Yu, J.; Ho, W. Review on the improvement of the photocatalytic and antibacterial activities of ZnO. J. Alloys Compd. 2017, 727, 792–820. [Google Scholar] [CrossRef]
- Singh, T.A.; Das, J.; Sil, P.C. Zinc oxide nanoparticles: A comprehensive review on its synthesis, anticancer and drug delivery applications as well as health risks. Adv. Colloid Interface Sci. 2020, 286, 102317. [Google Scholar] [CrossRef] [PubMed]
- Suresh, J.; Pradheesh, G.; Alexramani, V.; Sundrarajan, M.; Hong, S.I. Green synthesis and characterization of zinc oxide nanoparticle using insulin plant (Costus pictus D. Don) and investigation of its antimicrobial as well as anticancer activities. Adv. Nat. Sci. Nanosci. Nanotechnol. 2018, 9, 015008. [Google Scholar] [CrossRef]
- Karthik, S.; Siva, P.; Balu, K.S.; Suriyaprabha, R.; Rajendran, V.; Maaza, M. Acalypha indica–mediated green synthesis of ZnO nanostructures under differential thermal treatment: Effect on textile coating, hydrophobicity, UV resistance, and antibacterial activity. Adv. Powder Technol. 2017, 28, 3184–3194. [Google Scholar] [CrossRef]
- Kumar, V.; Anthony, S. Surface Chemistry of Nanobiomaterials; Elsevier: Amsterdam, The Netherlands, 2016. [Google Scholar]
- Maryanti, E.; Damayanti, D.; Gustian, I. Synthesis of ZnO nanoparticles by hydrothermal method in aqueous rinds extracts of Sapindus rarak DC. Mater. Lett. 2014, 118, 96–98. [Google Scholar] [CrossRef]
- Çolak, H.; Karaköse, E. Green synthesis and characterization of nanostructured ZnO thin films using Citrus aurantifolia (lemon) peel extract by spin-coating method. J. Alloys Compd. 2017, 690, 658–662. [Google Scholar] [CrossRef]
- Ambika, S.; Sundrarajan, M. Green biosynthesis of ZnO nanoparticles using Vitex negundo L. extract: Spectroscopic investigation of interaction between ZnO nanoparticles and human serum albumin. J. Photochem. Photobiol. B Biol. 2015, 149, 143–148. [Google Scholar] [CrossRef]
- Vijayakumar, E.; Kang, S.H.; Ahn, K.S. Facile electrochemical synthesis of manganese cobalt sulfide counter electrode for quantum dot-sensitized solar cells. J. Electrochem. Soc. 2018, 165, F375. [Google Scholar] [CrossRef]
- Bhuyar, P.; Rahim, M.H.A.; Sundararaju, S.; Ramaraj, R.; Maniam, G.P.; Govindan, N. Synthesis of silver nanoparticles using marine macroalgae Padina sp. and its antibacterial activity towards pathogenic bacteria. Beni-Suef. Univ. J. Basic Appl. Sci. 2020, 9, 1–15. [Google Scholar] [CrossRef] [Green Version]
- Khan, R.; Inam, M.A.; Park, D.R.; Zam Zam, S.; Yeom, I.T. Taguchi Orthogonal Array Dataset for the Effect of Water Chemistry on Aggregation of ZnO Nanoparticles. Data 2018, 3, 21. [Google Scholar] [CrossRef] [Green Version]
- Vidhya, E.; Vijayakumar, S.; Prathipkumar, S.; Praseetha, P. Green way biosynthesis: Characterization, antimicrobial and anticancer activity of ZnO nanoparticles. Gene Rep. 2020, 20, 100688. [Google Scholar] [CrossRef]
- Padalia, H.; Chanda, S. Characterization, antifungal and cytotoxic evaluation of green synthesized zinc oxide nanoparticles using Ziziphus nummularia leaf extract. Artif. Cells Nanomed. Biotechnol. 2017, 45, 1751–1761. [Google Scholar] [CrossRef] [Green Version]
- Yedurkar, S.; Maurya, C.; Mahanwar, P. Biosynthesis of zinc oxide nanoparticles using ixora coccinea leaf extract—a green approach. Open J. Synth. Theory Appl. 2016, 5, 1–14. [Google Scholar] [CrossRef] [Green Version]
- Fuku, X.; Kaviyarasu, K.; Matinise, N.; Maaza, M. Punicalagin green functionalized Cu/Cu2O/ZnO/CuO nanocomposite for potential electrochemical transducer and catalyst. Nanoscale Res. Lett. 2016, 11, 1–12. [Google Scholar] [CrossRef] [PubMed] [Green Version]
- Vickers, N.J. Animal communication: When I’m calling you, will you answer too? Curr. Biol. 2017, 27, R713–R715. [Google Scholar] [CrossRef] [PubMed]
- Sankar, R.; Karthik, A.; Prabu, A.; Karthik, S.; Shivashangari, K.S.; Ravikumar, V. Origanum vulgare mediated biosynthesis of silver nanoparticles for its antibacterial and anticancer activity. Colloids Surf. B Biointerfaces 2013, 108, 80–84. [Google Scholar] [CrossRef] [PubMed]
- Brđanin, S.; Bogdanović, N.; Kolundžić, M.; Milenković, M.; Golić, N.; Kojić, M.; Kundaković, T. Antimicrobial activity of oregano (Origanum vulgare L.): And basil (Ocimum basilicum L.): Extracts. Adv. Technol. 2015, 4, 5–10. [Google Scholar] [CrossRef] [Green Version]
- Preuss, H.G.; Echard, B.; Enig, M.; Brook, I.; Elliott, T.B. Minimum inhibitory concentrations of herbal essential oils and monolaurin for gram-positive and gram-negative bacteria. Mol. Cell Biochem. 2005, 272, 29–34. [Google Scholar] [CrossRef]
- Coccimiglio, J.; Alipour, M.; Jiang, Z.H.; Gottardo, C.; Suntres, Z. Antioxidant, Antibacterial, and Cytotoxic Activities of the Ethanolic Origanum vulgare Extract and Its Major Constituents. Oxid. Med. Cell Longev. 2016, 2016, 1404505. [Google Scholar] [CrossRef] [Green Version]
- Rossi, C.; Chaves-López, C.; Serio, A.; Anniballi, F.; Valbonetti, L.; Paparella, A. Effect of Origanum vulgare essential oil on biofilm formation and motility capacity of Pseudomonas fluorescens strains isolated from discoloured Mozzarella cheese. J. Appl. Microbiol. 2018, 124, 1220–1231. [Google Scholar] [CrossRef]
- Aslam, B.; Wang, W.; Arshad, M.I.; Khurshid, M.; Muzammil, S.; Rasool, M.H.; Nisar, M.A.; Alvi, R.F.; Aslam, M.A.; Qamar, M.U. Antibiotic resistance: A rundown of a global crisis. Infect. Drug Resist. 2018, 11, 1645. [Google Scholar] [CrossRef] [PubMed] [Green Version]
- Fair, R.J.; Tor, Y. Antibiotics and bacterial resistance in the 21st century. Perspect. Med. Chem. 2014, 6, S14459. [Google Scholar] [CrossRef] [PubMed] [Green Version]
- Bathoi, N.; Lone, S.A.; Marimani, M.; Wani, M.Y.; Al-Bogami, A.S.; Ahmad, A. Citral and its derivatives inhibit quorum sensing and biofilm formation in Chromobacterium Violaceum. Arch. Microbiol. 2021, 203, 1451–1459. [Google Scholar] [CrossRef]
- Abebe, G.M. The Role of Bacterial Biofilm in Antibiotic Resistance and Food Contamination. Int. J. Microbiol. 2020, 2020, 1705814. [Google Scholar] [CrossRef]
- Duran, N.; Menck, C.F. Chromobacterium violaceum: A review of pharmacological and industrial perspectives. Crit. Rev. Microbiol. 2001, 27, 201–222. [Google Scholar] [CrossRef] [PubMed]
- Duran, N.; Justo, G.Z.; Ferreira, C.V.; Melo, P.S.; Cordi, L.; Martins, D. Violacein: Properties and biological activities. Biotechnol. Appl. Biochem. 2007, 48, 127–133. [Google Scholar]
- Duran, N.; Justo, G.Z.; Duran, M.; Brocchi, M.; Cordi, L.; Tasic, L.; Castro, G.R.; Nakazato, G. Advances in Chromobacterium violaceum and properties of violacein-its main secondary metabolite: A review. Biotechnol. Adv. 2016, 34, 1030–1045. [Google Scholar] [CrossRef]
- Batista, J.H.; da Silva Neto, J.F. Chromobacterium violaceum Pathogenicity: Updates and insights from genome sequencing of novel Chromobacterium species. Front. Microbiol. 2017, 8, 2213. [Google Scholar] [CrossRef]
- Adonizio, A.; Kong, K.F.; Mathee, K. Inhibition of quorum sensing-controlled virulence factor production in Pseudomonas aeruginosa by South Florida plant extracts. Antimicrobrobial. Agents Chemother. 2008, 52, 198–203. [Google Scholar] [CrossRef] [Green Version]
- Deep, A.; Chaudhary, U.; Gupta, V. Quorum sensing and bacterial pathogenicity: From molecules to disease. J. Lab. Phys. 2011, 3, 4. [Google Scholar] [CrossRef]
- Ahmad, A.; Viljoen, A.; Chenia, H. The impact of plant volatiles on bacterial quorum sensing. Lett. Appl. Microbiol. 2015, 60, 8–19. [Google Scholar] [CrossRef] [PubMed]
- Zhu, H.; He, C.C.; Chu, Q.H. Inhibition of quorum sensing in Chromobacterium violaceum by pigments extracted from Auricularia auricular. Lett. Appl. Microbiol. 2011, 52, 269–274. [Google Scholar] [CrossRef]
- Makabenta, J.M.V.; Nabawy, A.; Li, C.-H.; Schmidt-Malan, S.; Patel, R.; Rotello, V.M. Nanomaterial-based therapeutics for antibiotic-resistant bacterial infections. Nat. Rev. Microbiol. 2021, 19, 23–36. [Google Scholar] [CrossRef] [PubMed]
- Hayat, S.; Muzammil, S.; Aslam, B.; Siddique, M.H.; Saqalein, M.; Nisar, M.A. Quorum quenching: Role of nanoparticles as signal jammers in Gram-negative bacteria. Future Microbiol. 2019, 14, 61–72. [Google Scholar] [CrossRef]
- Gómez-Gómez, B.; Arregui, L.; Serrano, S.; Santos, A.; Pérez-Corona, T.; Madrid, Y. Selenium and tellurium-based nanoparticles as interfering factors in quorum sensing-regulated processes: Violacein production and bacterial biofilm formation. Metallomics 2019, 11, 1104–1114. [Google Scholar] [CrossRef] [PubMed]
- Song, X.; Xia, Y.-X.; He, Z.-D.; Zhang, H.-J. A review of natural products with anti-biofilm activity. Curr. Org. Chem. 2018, 22, 789–817. [Google Scholar] [CrossRef]
- Jayachandran, A.; Aswathy, T.R.; Nair, A.S. Green synthesis and characterization of zinc oxide nanoparticles using Cayratia pedata leaf extract. Biochem. Biophys. Rep. 2021, 8, 100995. [Google Scholar]
- Rajiv, P.; Rajeshwari, S.; Venckateh, R. Bio-fabrication of zinc oxide nanoparticles using leaf extract of Parthenium hysterophorus L. and its size-dependent antifungal activity against plant fungal pathogens. Spectrochim. Acta A Mol. Biomol. Spectrosc. 2013, 112, 384–387. [Google Scholar] [CrossRef] [PubMed]
- Senthilkumar, N.; Nandhakumar, E.; Priya, P.; Soni, D.; Vimalan, M.; Vetha Potheher, I. Synthesis of ZnO nanoparticles using leaf extract of Tectona grandis (L.) and their anti-bacterial, anti-arthritic, anti-oxidant and in vitro cytotoxicity activities. New J. Chem. 2017, 41, 10347–10356. [Google Scholar] [CrossRef]
- Sybiya Vasantha Packiavathy, I.A.; Agilandeswari, P.; Musthafa, K.S.; Pandian, S.K.; Ravi, A.V. Antibiofilm and quorum sensing inhibitory potential of Cuminum cyminum and its secondary metabolite methyl eugenol against Gram negative bacterial pathogens. Food Res. Int. 2012, 45, 85–92. [Google Scholar] [CrossRef]
- Ravichandran, V.; Zhong, L.; Wang, H.; Yu, G.; Zhang, Y.; Li, A. Virtual screening and biomolecular interactions of CviR-based quorum sensing inhibitors against Chromobacterium violaceum. Front. Cell. Infect. Microbiol. 2018, 8, 292. [Google Scholar] [CrossRef]
- Albano, S.M.; Miguel, M.G. Biological activities of extracts of plants grown in Portugal. Ind. Crop. Prod. 2011, 33, 338–343. [Google Scholar] [CrossRef]
- Umavathi, S.; Mahboob, S.; Govindarajan, M.; Al-Ghanim, K.A.; Ahmed, Z.; Norah Al-Mulhm, P.V.; Subash, M.; Gopinath, K.; Kavitha, C. Green synthesis of ZnO nanoparticles for antimicrobial and vegetative growth applications: A novel approach for advancing efficient high quality health care to human wellbeing. Saudi J. Biol. Sci. 2021, 28, 1808–1815. [Google Scholar] [CrossRef]
- Jobie, F.N.; Ranjbar, M.; Moghaddam, A.H.; Kiani, M. Green synthesis of zinc oxide nanoparticles using Amygdalus scoparia Spach stem bark extract and their applications as an alternative antimicrobial, anticancer, and antidiabetic agent. Adv. Powder Technol. 2021, 32, 2043–2052. [Google Scholar] [CrossRef]
- Yin, H.; Fretté, X.C.; Christensen, L.P.; Grevsen, K. Chitosan oligosaccharides promote the content of polyphenols in Greek Oregano (Origanum vulgare ssp. hirtum). J. Agric. Food Chem. 2012, 60, 136–143. [Google Scholar] [CrossRef] [PubMed]
- Vale-Silva, L.; Silva, M.J.; Oliveira, D.; Gonçalves, M.J.; Cavaleiro, C.; Salgueiro, L.; Pinto, E. Correlation of the chemical composition of essential oils from Origanum vulgare subsp. virens with their in vitro activity against pathogenic yeasts and filamentous fungi. J. Med. Microbiol. 2012, 61, 252–260. [Google Scholar] [CrossRef]
- Lemhadri, A.; Zeggwagh, N.A.; Maghrani, M.; Jouad, H.; Eddouks, M. Antihyperglycaemic activity of the aqueous extract of Origanum vulgare growing wild in Tafilalet region. J. Ethnopharmacol. 2004, 92, 251–256. [Google Scholar] [CrossRef]
- Stashenko, E.E.; Puertas, M.A.; Martinez, J.R. SPME determination of volatile aldehydes for evaluation of in vitro anti-oxidant activity. Anal. Bioanal. Chem. 2002, 373, 70–74. [Google Scholar] [CrossRef]
- Liang, C.H.; Chan, L.P.; Ding, H.Y.; So, E.C.; Lin, R.J.; Wang, H.M.; Chen, Y.G.; Chou, T.H. Free radical scavenging activity of 4-(3,4-Dihydroxybenzoyloxymethyl)phenyl-O-bD-glucopyranoside from Origanum vulgare and its protection against oxidative damage. J. Agric. Food Chem. 2012, 60, 7690–7696. [Google Scholar] [CrossRef]
- Saxena, M.; Saxena, J.; Pradhan, A. Flavonoids and phenolic acids as antioxidants in plants and human health. Int. J. Pharm. Sci. Rev. Res. 2012, 16, 130–134. [Google Scholar]
- Knez Hrnčič, M.; Cör, D.; Simonovska, J.; Knez, Ž.; Kavrakovski, Z.; Rafajlovska, V. Extraction Techniques and Analytical Methods for Characterization of Active Compounds in Origanum Species. Molecules 2020, 25, 4735. [Google Scholar] [CrossRef]
- Gutiérrez-Grijalva, E.P.; Picos-Salas, M.A.; Leyva-López, N.; Criollo-Mendoza, M.S.; Vazquez-Olivo, G.; Heredia, J.B. Flavonoids and Phenolic Acids from Oregano: Occurrence, Biological Activity and Health Benefits. Plants 2018, 7, 2. [Google Scholar] [CrossRef] [PubMed] [Green Version]
- Yanishlieva-Maslarova, N.V.; Heinonen, I.M. Sources of natural antioxidants: Vegetables, fruits, herbs, spices and teas. In Woodhead Publishing Series in Food Science, Technology and Nutrition, Antioxidants in Food; Pokorny, J., Yanishlieva, N., Gordon, M., Eds.; Woodhead Publishing: Cambridge, UK, 2001; pp. 210–263. [Google Scholar]
- Lin, P.C.; Lin, S.; Wang, P.C.; Sridhar, R. Techniques for physicochemical characterization of nanomaterials. Biotechnol. Adv. 2014, 32, 711–726. [Google Scholar] [CrossRef] [PubMed] [Green Version]
- Ansari, S.A.; Ansari, S.; Foaud, H.; Cho, M.H. Facile and sustainable synthesis of carbon-doped ZnO nanostructures towards the superior visible light photocatalytic performance. New J. Chem. 2017, 41, 9314–9320. [Google Scholar] [CrossRef]
- Muniz, F.T.L.; Miranda, M.A.R.; Morilla dos Santos, C.; Sasaki, J.M. The Scherrer equation and the dynamical theory of X-ray diffraction. Acta Crystallogr. Sect. A Found. Adv. 2016, 72, 385–390. [Google Scholar] [CrossRef] [PubMed]
- Cullity, B.D. Elements of X-ray Diffraction; Addison-Wesley Publishing: Boston, MA, USA, 1956. [Google Scholar]
- Biju, V.; Sugathan, N.; Vrinda, V.; Salini, S. Estimation of lattice strain in nanocrystalline silver from X-ray diffraction line broadening. J. Mater. Sci. 2008, 43, 1175–1179. [Google Scholar] [CrossRef]
- Williamson, G.; Hall, W. X-ray line broadening from filed aluminium and wolfram. Acta Metall. 1953, 1, 22–31. [Google Scholar] [CrossRef]
- Prasad, A.S. Green synthesis of nanocrystalline manganese (II, III) oxide. Mater. Sci. Semicond. Process. 2017, 71, 342–347. [Google Scholar] [CrossRef]
- Azizi, S.; Mahdavi Shahri, M.; Mohamad, R. Green Synthesis of Zinc Oxide Nanoparticles for Enhanced Adsorption of Lead Ions from Aqueous Solutions: Equilibrium, Kinetic and Thermodynamic Studies. Molecules 2017, 22, 831. [Google Scholar] [CrossRef]
- Kumar, A.; Dixit, C.K. Methods for characterization of nanoparticles. In Advances in Nanomedicine for the Delivery of Therapeutic Nucleic Acids; Woodhead Publishing: Cambridge, UK, 2017; pp. 43–58. [Google Scholar]
- Modena, M.M.; Rühle, B.; Burg, T.P.; Wuttke, S. Nanoparticle Characterization: What to Measure? Adv Mater. 2019, 31, 1901556. [Google Scholar] [CrossRef]
- Vimala, K.; Sundarraj, S.; Paulpandi, M.; Vengatesan, S.; Kannan, S. Green synthesized doxorubicin loaded zinc oxide nanoparticles regulates the Bax and Bcl-2 expression in breast and colon carcinoma. Process Biochem. 2014, 49, 160–172. [Google Scholar] [CrossRef]
- Lynch, I.; Dawson, K.A. Protein-nanoparticle interactions. Nano Today 2008, 3, 40–47. [Google Scholar] [CrossRef]
- Chauhan, A.K.; Kataria, N.; Garg, V.K. Green fabrication of ZnO nanoparticles using Eucalyptus spp. leaves extract and their application in wastewater remediation. Chemosphere 2020, 247, 125803. [Google Scholar] [CrossRef]
- D’Souza, J.N.; Nagaraja, G.K.; Navada, K.M.; Kouser, S.; Nityasree, B.R.; Manasa, D.J. An ensuing repercussion of solvent alteration on biological and photocatalytic efficacy of Emilia sonchifolia (L.) phytochemicals capped zinc oxide nanoparticles. Colloids Surf. A Physicochem. Eng. Asp. 2021, 627, 127162. [Google Scholar] [CrossRef]
- Zhang, J.; Sun, L.D.; Lin, Y.J.; Su, H.; Liao, C.; Yan, C. Control of ZnO morphology via a simple solution route. Chem. Mater. 2002, 14, 4172–4177. [Google Scholar] [CrossRef]
- Vijayakumar, S.; Vinoj, G.; Malaikozhundan, B.; Shanthi, S.; Vaseeharan, B. Plectranthus amboinicus leaf extract mediated synthesis of zinc oxide nanoparticles and its control of methicillin resistant Staphylococcus aureus biofilm and blood sucking mosquito larvae. Spectrochim. Acta A. Mol. Biomol. Spectrosc. 2015, 137, 889–891. [Google Scholar] [CrossRef] [PubMed]
- Divya, M.J.; Sowmia, C.; Joona, K.; Dhanya, K.P. Synthesis of zinc oxide nanoparticle from Hibiscus rosa sinensis leaf extract and investigation of its antimicrobial activity. Res. J. Pharm. Biol. Chem. Sci. 2013, 4, 1137–1142. [Google Scholar]
- Shafique, S.; Jabeen, N.; Ahmad, K.S.; Irum, S.; Anwaar, S.; Ahmad, N.; Alam, S.; Ilyas, M.; Khan, T.F.; Hussain, S.Z. Green fabricated zinc oxide nanoformulated media enhanced callus induction and regeneration dynamics of Panicum virgatum L. PLoS ONE 2020, 15, e0230464. [Google Scholar] [CrossRef]
- Al-Kordy, H.M.H.; Sabry, S.A.; Mabrouk, M.E.M. Statistical optimization of experimental parameters for extracellular synthesis of zinc oxide nanoparticles by a novel haloalaliphilic Alkalibacillus sp.W7. Sci Rep. 2021, 11, 10924. [Google Scholar] [CrossRef]
- Radini, I.A.; Hasan, N.; Malik, M.A.; Khan, Z. Biosynthesis of iron nanoparticles using Trigonella foenum-graecum seed extract for photocatalytic methyl orange dye degradation and antibacterial applications. J. Photochem. Photobiol. B 2018, 183, 154–163. [Google Scholar] [CrossRef]
- Albeladi, S.S.R.; Malik, M.A.; Al-thabaiti, S.A. Facile biofabrication of silver nanoparticles using Salvia officinalis leaf extract and its catalytic activity towards Congo red dye degradation. J. Mater. Res. Technol. 2020, 9, 10031–10044. [Google Scholar] [CrossRef]
- Puchalski, M.; Dąbrowski, P.; Olejniczak, W.; Krukowski, P.; Kowalczyk, P.; Polański, K. The study of silver nanoparticles by scanning electron microscopy, energy dispersive X-ray analysis and scanning tunnelling microscopy. Mater. Sci.-Pol. 2007, 25, 473–478. [Google Scholar]
- Vijayakumar, S.; Vaseeharan, B.; Malaikozhundan, B.; Shobiya, M. Laurus nobilis leaf extract mediated green synthesis of ZnO nanoparticles: Characterization and biomedical applications. Biomed. Pharm. 2016, 84, 1213–1222. [Google Scholar] [CrossRef]
- Jamdagni, P.; Khatri, P.; Rana, J.S. Green synthesis of zinc oxide nanoparticles using flower extract of Nyctanthes arbor-tristis and their antifungal activity. J. King Saud Univ.-Sci. 2018, 30, 168–175. [Google Scholar] [CrossRef] [Green Version]
- Moghaddam, A.B.; Moniri, M.; Azizi, S.; Rahim, R.A.; Ariff, A.B.; Saad, W.Z.; Namvar, F.; Navaderi, M.; Mohamad, R. Biosynthesis of ZnO Nanoparticles by a New Pichia kudriavzevii Yeast Strain and Evaluation of Their Antimicrobial and Antioxidant Activities. Molecules 2017, 22, 872. [Google Scholar] [CrossRef] [PubMed] [Green Version]
- Moghrovyan, A.; Sahakyan, N.; Babayan, A.; Chichoyan, N.; Petrosyan, M.; Trchounian, A. Essential oil and ethanol extract of oregano (Origanum vulgare L.) from Armenian flora as a natural source of terpenes, flavonoids and other phytochemicals with antiradical, antioxidant, metal chelating, tyrosinase inhibitory and antibacterial activity. Curr. Pharm. Des. 2019, 25, 1809–1816. [Google Scholar] [CrossRef]
- Suresh, D.; Nethravathi, P.; Rajanaika, H.; Nagabhushana, H.; Sharma, S. Green synthesis of multifunctional zinc oxide (ZnO) nanoparticles using Cassia fistula plant extract and their photodegradative, antioxidant and antibacterial activities. Mater. Sci. Semicond. Process. 2015, 31, 446–454. [Google Scholar] [CrossRef]
- Yuvakkumar, R.; Suresh, J.; Saravanakumar, B.; Nathanael, A.J.; Hong, S.I.; Rajendran, V. Rambutan peels promoted biomimetic synthesis of bioinspired zinc oxide nanochains for biomedical applications. Spectrochim. Acta Part A Mol. Biomol. Spectrosc. 2015, 137, 250–258. [Google Scholar] [CrossRef]
- Thi, T.U.D.; Nguyen, T.T.; Thi, Y.D.; Thi, K.H.T.; Phan, B.T.; Pham, K.N. Green synthesis of ZnO nanoparticles using orange fruit peel extract for antibacterial activities. RSC Adv. 2020, 10, 23899–23907. [Google Scholar]
- Jiang, Q.; Chen, J.; Yang, C.; Yin, Y.; Yao, K. Quorum sensing: A prospective therapeutic target for bacterial diseases. BioMed Res. Int. 2019, 2019, 2015978. [Google Scholar] [CrossRef] [PubMed] [Green Version]
- Wang, L.; Hu, C.; Shao, L. The antimicrobial activity of nanoparticles: Present situation and prospects for the future. Int. J. Nanomed. 2017, 12, 1227. [Google Scholar] [CrossRef] [PubMed] [Green Version]
- Loo, Y.Y.; Rukayadi, Y.; Nor-Khaizura, M.-A.-R.; Kuan, C.H.; Chieng, B.W.; Nishibuchi, M.; Radu, S. In vitro antimicrobial activity of green synthesized silver nanoparticles against selected gram-negative foodborne pathogens. Front. Microbiol. 2018, 9, 1555. [Google Scholar] [CrossRef] [PubMed]
- Ilk, S.; Tan, G.; Emül, E.; Sağlam, N. Investigation the potential use of silver nanoparticles synthesized by propolis extract as N-acyl-homoserine lactone-mediated quorum sensing systems inhibitor. Turk. J. Med. Sci. 2020, 50, 1147–1156. [Google Scholar] [CrossRef] [PubMed]
- Singh, P.; Garg, A.; Pandit, S.; Mokkapati, V.; Mijakovic, I. Antimicrobial effects of biogenic nanoparticles. Nanomaterials 2018, 8, 1009. [Google Scholar] [CrossRef] [Green Version]
- Shah, S.; Gaikwad, S.; Nagar, S.; Kulshrestha, S.; Vaidya, V.; Nawani, N.; Pawar, S. Biofilm inhibition and anti-quorum sensing activity of phytosynthesized silver nanoparticles against the nosocomial pathogen Pseudomonas aeruginosa. Biofouling 2019, 35, 34–49. [Google Scholar] [CrossRef] [Green Version]
- Miller, M.B.; Bassler, B.L. Quorum sensing in bacteria. Annu. Rev. Microbiol. 2001, 55, 165–199. [Google Scholar] [CrossRef] [PubMed] [Green Version]
- Roy, R.; Tiwari, M.; Donelli, G.; Tiwari, V. Strategies for combating bacterial biofilms: A focus on anti-biofilm agents and their mechanisms of action. Virulence 2018, 9, 522–554. [Google Scholar] [CrossRef]
- Stauff, D.L.; Bassler, B.L. Quorum sensing in Chromobacterium violaceum: DNA recognition and gene regulation by the CviR receptor. J. Bacteriol. 2011, 193, 3871–3878. [Google Scholar] [CrossRef] [Green Version]
- Deryabin, D.G.; Inchagova, K.S. Inhibitory effect of aminoglycosides and tetracyclines on quorum sensing in Chromobacterium violaceum. Microbiology 2018, 87, 1–8. [Google Scholar] [CrossRef]
- Mohanta, Y.K.; Biswas, K.; Jena, S.K.; Hashem, A.; Abd_Allah, E.F.; Mohanta, T.K. Anti-biofilm and antibacterial activities of silver nanoparticles synthesized by the reducing activity of phytoconstituents present in the Indian medicinal plants. Front. Microbiol. 2020, 11, 1143. [Google Scholar] [CrossRef]
- Chang, Y.; Wang, P.-C.; Ma, H.-M.; Chen, S.-Y.; Fu, Y.-H.; Liu, Y.-Y.; Wang, X.; Yu, G.-C.; Huang, T.; Hibbs, D.E. Design, synthesis and evaluation of halogenated furanone derivatives as quorum sensing inhibitors in Pseudomonas aeruginosa. Eur. J. Pharm. Sci. 2019, 140, 105058. [Google Scholar] [CrossRef] [PubMed]
- Leng, D.; Li, Y.; Zhu, J.; Liang, R.; Zhang, C.; Zhou, Y.; Li, M.; Wang, Y.; Rong, D.; Wu, D. The antibiofilm activity and mechanism of nanosilver-and nanozinc-incorporated mesoporous calcium-silicate nanoparticles. Int. J. Nanomed. 2020, 15, 3921. [Google Scholar] [CrossRef] [PubMed]
- Fan, W.; Li, Y.; Sun, Q.; Ma, T.; Fan, B. Calcium-silicate mesoporous nanoparticles loaded with chlorhexidine for both anti- Enterococcus faecalis and mineralization properties. J. Nanobiotechnol. 2016, 14, 1–12. [Google Scholar] [CrossRef] [PubMed] [Green Version]
- Lebeaux, D.; Ghigo, J.-M.; Beloin, C. Biofilm-related infections: Bridging the gap between clinical management and fundamental aspects of recalcitrance toward antibiotics. Microbiol. Mol. Biol. Rev. 2014, 78, 510–543. [Google Scholar] [CrossRef] [Green Version]
- Hǿibya, N.; Bjarnsholt, T.; Givskov, M.; Molin, S.; Ciofu, O. Antibiotic resistance of bacterial biofilms. Int. J. Antimic. Agents 2010, 35, 322–332. [Google Scholar] [CrossRef] [Green Version]
- Rasko, D.A.; Moreira, C.G.; Reading, N.C.; Ritchie, J.M.; Waldor, M.K.; Williams, N.; Taussig, R.; Wei, S.; Roth, M.; Hughes, D.T. Targeting QseC signaling and virulence for antibiotic development. Science 2008, 321, 1078–1080. [Google Scholar] [CrossRef] [Green Version]
- Burt, S.A.; Ojo-Fakunle, V.T.; Woertman, J.; Veldhuizen, E.J. The natural antimicrobial carvacrol inhibits quorum sensing in Chromobacterium violaceum and reduces bacterial biofilm formation at sub-lethal concentrations. PLoS ONE 2014, 9, e93414. [Google Scholar] [CrossRef] [Green Version]
- Devescovi, G.; Kojic, M.; Covaceuszach, S.; Cámara, M.; Williams, P.; Bertani, I.; Subramoni, S.; Venturi, V. Negative Regulation of Violacein Biosynthesis in Chromobacterium violaceum. Front. Microbiol. 2017, 8, 349. [Google Scholar] [CrossRef] [Green Version]
- Singh, B.; Singh, B.; Singh, A.; Khan, W.; Naqvi, A.H.; Singh, H.B. Mycofabricated biosilver nanoparticles interrupt Pseudomonas aeruginosa quorum sensing systems. Sci. Rep. 2015, 5, 13719. [Google Scholar] [CrossRef]
- Liu, Z.; Wang, W.; Zhu, Y.; Gong, Q.; Yu, W.; Lu, X. Antibiotics at subinhibitory concentrations improve the quorum sensing behavior of Chromobacterium violaceum. FEMS Microbiol. Lett. 2013, 341, 37–44. [Google Scholar] [CrossRef] [Green Version]

| Position (2θ°) | Crystallographic Planes (hkl) | d-Spacing (Å) | FWHM | Crystallite Size (d) (nm) |
|---|---|---|---|---|
| 32.13 | 100 | 2.78338 | 0.37383 | 22.11 |
| 34.82 | 002 | 2.57389 | 0.29024 | 28.68 |
| 36.67 | 101 | 2.44856 | 0.42528 | 19.67 |
| 47.91 | 102 | 1.89688 | 0.42229 | 20.58 |
| 56.95 | 110 | 1.61550 | 0.37656 | 24.00 |
| 63.22 | 103 | 1.46946 | 0.41969 | 22.22 |
| 66.46 | 200 | 1.40563 | 0.40421 | 23.49 |
| 68.34 | 112 | 1.37135 | 0.40952 | 23.44 |
| 69.48 | 201 | 1.35163 | 0.33586 | 28.78 |
| 72.90 | 004 | 1.29644 | 0.42515 | 23.23 |
| 77.41 | 202 | 1.23178 | 0.48021 | 21.20 |
| Nanoparticles | MIC (μg/mL) | MBC (μg/mL) | MQSIC (μg/mL) | ZoT (MIC) |
|---|---|---|---|---|
| Biogenic ZnO NPs | 4 | 16 | 1 | 19 ± 0.03 |
| Ampicillin | 2 | 4 | Not tested | Not tested |
Publisher’s Note: MDPI stays neutral with regard to jurisdictional claims in published maps and institutional affiliations. |
© 2021 by the authors. Licensee MDPI, Basel, Switzerland. This article is an open access article distributed under the terms and conditions of the Creative Commons Attribution (CC BY) license (https://creativecommons.org/licenses/by/4.0/).
Share and Cite
Kamli, M.R.; Malik, M.A.; Srivastava, V.; Sabir, J.S.M.; Mattar, E.H.; Ahmad, A. Biogenic ZnO Nanoparticles Synthesized from Origanum vulgare Abrogates Quorum Sensing and Biofilm Formation in Opportunistic Pathogen Chromobacterium violaceum. Pharmaceutics 2021, 13, 1743. https://doi.org/10.3390/pharmaceutics13111743
Kamli MR, Malik MA, Srivastava V, Sabir JSM, Mattar EH, Ahmad A. Biogenic ZnO Nanoparticles Synthesized from Origanum vulgare Abrogates Quorum Sensing and Biofilm Formation in Opportunistic Pathogen Chromobacterium violaceum. Pharmaceutics. 2021; 13(11):1743. https://doi.org/10.3390/pharmaceutics13111743
Chicago/Turabian StyleKamli, Majid Rasool, Maqsood Ahmad Malik, Vartika Srivastava, Jamal S. M. Sabir, Ehab H. Mattar, and Aijaz Ahmad. 2021. "Biogenic ZnO Nanoparticles Synthesized from Origanum vulgare Abrogates Quorum Sensing and Biofilm Formation in Opportunistic Pathogen Chromobacterium violaceum" Pharmaceutics 13, no. 11: 1743. https://doi.org/10.3390/pharmaceutics13111743
APA StyleKamli, M. R., Malik, M. A., Srivastava, V., Sabir, J. S. M., Mattar, E. H., & Ahmad, A. (2021). Biogenic ZnO Nanoparticles Synthesized from Origanum vulgare Abrogates Quorum Sensing and Biofilm Formation in Opportunistic Pathogen Chromobacterium violaceum. Pharmaceutics, 13(11), 1743. https://doi.org/10.3390/pharmaceutics13111743

